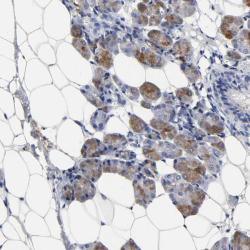

sc-5808
antibody from Santa Cruz Biotechnology
Targeting: CCL21
6Ckine, CKb9, ECL, exodus-2, SCYA21, SLC, TCA4
Antibody data
- Antibody Data
- Antigen structure
- References [1]
- Comments [0]
- Validations
- Immunohistochemistry [1]
Submit
Validation data
Reference
Comment
Report error
- Product number
- sc-5808 - Provider product page

- Provider
- Santa Cruz Biotechnology
- Proper citation
- Santa Cruz Biotechnology Cat#sc-5808, RRID:AB_2071925
- Product name
- Anti-CCL21
- Antibody type
- Polyclonal (Antigen purified)
- Antigen
- Synthetic peptide
- Reactivity
- Human
- Host
- Goat
Submitted references Up-regulation of the chemokine CCL21 in the skin of subjects exposed to irritants.
Eberhard Y, Ortiz S, Ruiz Lascano A, Kuznitzky R, Serra HM
BMC immunology 2004 Apr 26;5:7
BMC immunology 2004 Apr 26;5:7
No comments: Submit comment
Supportive validation
- Submitted by
- per
- Main image
- Experimental details
- Immunohistochemical staining of human salivary gland shows moderate positivity in subtypes of glandular cells.
- Validation comment
- Staining pattern partly consistent with experimental and/or bioinformatic data.